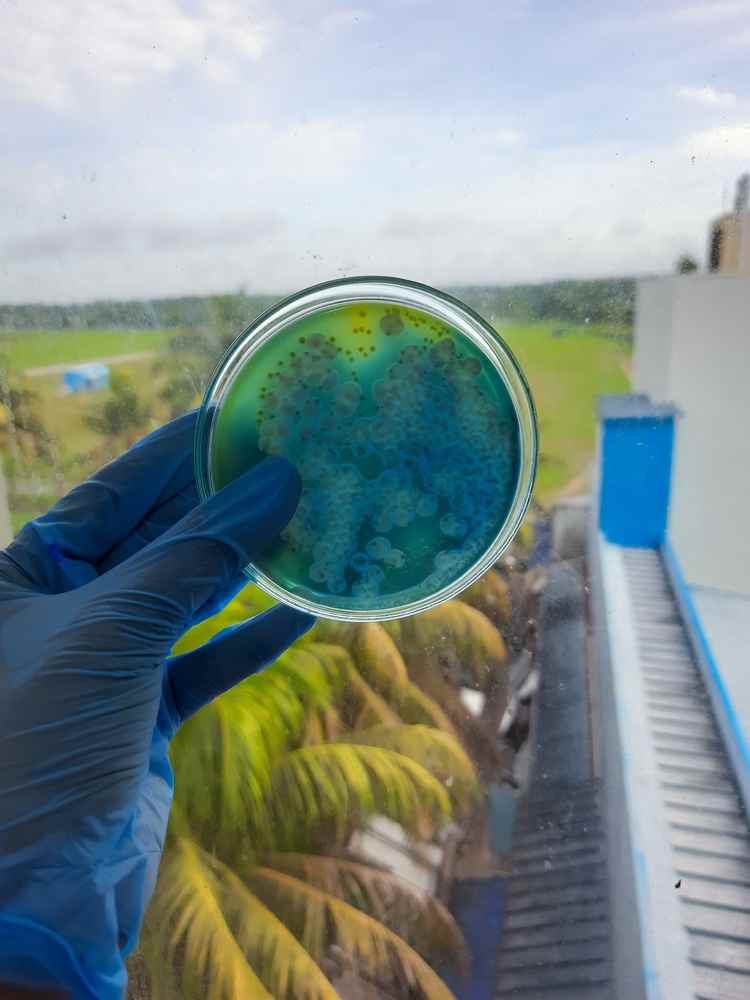
trực khuẩn gram âm ý nghĩa nhuộm gram
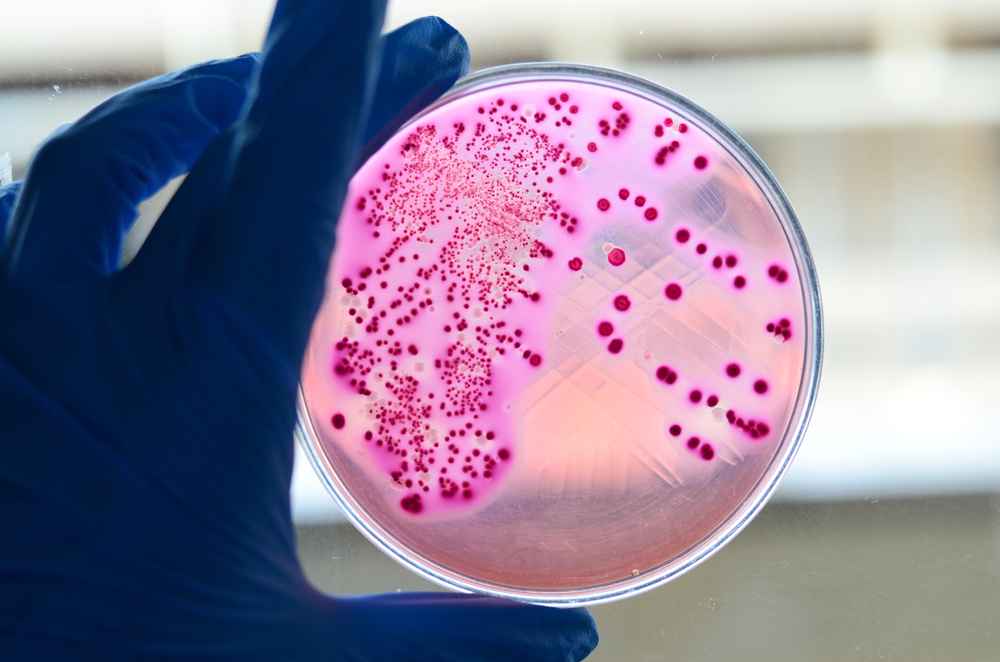
trực khuẩn gram âm trong bệnh lý

Trực khuẩn gram âm là gì? Cấu trúc và ý nghĩa trong nhuộm gram ra sao?
Trực khuẩn gram âm là gì?
Trực khuẩn gram âm là những vi khuẩn có hình dạng que thẳng hoặc hơi cong, thuộc nhóm vi khuẩn gram âm theo phân loại nhuộm gram, khi nhuộm theo phương pháp gram sẽ cho màu hồng hoặc đỏ dưới kính hiển vi.
Trực khuẩn gram âm thường tồn tại rộng rãi trong môi trường tự nhiên như đất, nước, hệ tiêu hóa của con người và động vật, cũng như trong môi trường bệnh viện. Chúng có thể trở thành tác nhân gây bệnh khi hệ miễn dịch của cơ thể suy yếu hoặc có các yếu tố thuận lợi như vết thương hở, thủ thuật y tế xâm lấn hoặc vệ sinh kém.
Khi nhuộm, vi khuẩn gram âm không giữ được màu tím tinh thể mà bị tẩy màu bởi cồn, sau đó nhuộm màu đỏ hoặc hồng bởi safranin. Đặc điểm này phản ánh thành tế bào mỏng hơn, với lớp peptidoglycan ít và có màng ngoài chứa lipopolysaccharide, còn gọi là nội độc tố, gây ra các phản ứng viêm mạnh mẽ trong cơ thể con người.
Trực khuẩn gram âm được chia thành hai nhóm chính
Nhóm trực khuẩn gram âm lên men đường:
Thường thuộc họ vi khuẩn đường ruột, có khả năng lên men glucose để sản sinh năng lượng.
Các đại diện điển hình bao gồm
Escherichia coli trực khuẩn đại tràng, Klebsiella pneumoniae trực khuẩn viêm phổi, Salmonella trực khuẩn thương hàn, Shigella trực khuẩn lỵ. Nhóm này thường gây nhiễm trùng đường ruột, tiết niệu và huyết.
Nhóm trực khuẩn gram âm không lên men đường:
Không sử dụng glucose qua quá trình lên men mà chỉ oxy hóa. Các loại phổ biến như Pseudomonas aeruginosa trực khuẩn mủ xanh, Acinetobacter baumannii, Burkholderia cepacia, Stenotrophomonas maltophilia.

Nhóm này thường gây nhiễm khuẩn bệnh viện, đặc biệt ở bệnh nhân suy giảm miễn dịch, với tỷ lệ phân lập khoảng 12 phần trăm trong tổng số vi khuẩn gây bệnh theo các nghiên cứu gần đây.
Trực khuẩn gram âm không chỉ là vi khuẩn gây bệnh mà một số còn là thành phần bình thường của hệ vi sinh vật trong cơ thể, như trong đường ruột hoặc vùng kín phụ nữ. Tuy nhiên, khi mất cân bằng, chúng có thể dẫn đến nhiễm trùng nghiêm trọng.
Cấu trúc tế bào của trực khuẩn gram âm
Cấu trúc tế bào của trực khuẩn gram âm khá phức tạp và khác biệt so với vi khuẩn gram dương, góp phần vào khả năng kháng thuốc và gây bệnh của chúng. Cụ thể:
- Nhân của trực khuẩn gram âm: Không có nhân thật mà là vùng nucleoid chứa ADN vòng đơn, không có màng bao quanh.
- Bào tương: Chứa ribosome, enzyme và các chất dinh dưỡng cần thiết cho sự sống.
- Màng bào tương: Lớp lipid kép, kiểm soát sự trao đổi chất và vận chuyển.
- Thành tế bào: Mỏng hơn vi khuẩn gram dương, với lớp peptidoglycan mỏng (chiếm khoảng 10 phần trăm thành tế bào), chứa lipid cao và
- không có axit teichoic. Lớp này quyết định tính âm gram.
- Màng ngoài: Đặc trưng của gram âm, chứa lipopolysaccharide nội độc tố gây sốt và sốc nhiễm trùng. Có không gian periplasm giữa màng ngoài và màng bào tương, chứa enzyme thủy phân.
- Vỏ bọc: Lớp polysaccharide bên ngoài, giúp vi khuẩn bám dính và tránh hệ miễn dịch.
- Lông và pili: Cấu trúc giúp di chuyển, bám dính vào tế bào và trao đổi gen như pili tình dục.
- Roi: Một số loại có roi để di chuyển, như Pseudomonas aeruginosa.

Cấu trúc này làm trực khuẩn gram âm dễ kháng penicillin do peptidoglycan mỏng nhưng nhạy cảm với một số kháng sinh khác, đồng thời nội độc tố gây phản ứng viêm mạnh.

Các loại trực khuẩn gram âm thường gặp và vai trò gây bệnh
Có hàng trăm loại trực khuẩn gram âm, nhưng một số phổ biến nhất bao gồm:
- Trực khuẩn mủ xanh Pseudomonas aeruginosa: Tồn tại trong nước, đất và môi trường bệnh viện. Gây nhiễm trùng vết thương, viêm tai ngoài, viêm giác mạc, viêm phổi liên quan thở máy, nhiễm trùng tiết niệu và nhiễm trùng huyết ở người suy giảm miễn dịch.
- Acinetobacter baumannii: Thường trú bệnh viện, gây viêm phổi bệnh viện, nhiễm trùng huyết với tỷ lệ kháng thuốc cao trên 70% với nhiều nhóm kháng sinh.
- Trực khuẩn đại tràng Escherichia coli: Thường trú đường ruột, gây tiêu chảy, nhiễm trùng tiết niệu, viêm phúc mạc, nhiễm trùng huyết.
- Klebsiella pneumoniae: Gây viêm phổi, nhiễm trùng tiết niệu, nhiễm trùng huyết.
- Salmonella: Gây thương hàn, tiêu chảy do thực phẩm ô nhiễm.
- Shigella: Gây lỵ trực khuẩn với triệu chứng tiêu chảy có máu và mủ.
- Các loại khác: Burkholderia cepacia gây nhiễm trùng ở bệnh nhân xơ nang phổi, Stenotrophomonas maltophilia nhiễm trùng hô hấp, Yersinia pestis dịch hạch, Vibrio cholerae bệnh tả, Bordetella pertussis ho gà.
Những vi khuẩn này thường trú trong môi trường, trở nên nguy hiểm khi xâm nhập qua da, niêm mạc, hô hấp hoặc tiêu hóa.
Phương pháp nhuộm Gram và cơ chế phân biệt trực khuẩn Gram âm
Nhuộm Gram là một kỹ thuật nhuộm vi phân differential staining quan trọng trong vi sinh học. Ban đầu, Gram phát triển phương pháp này để phân biệt vi khuẩn gây viêm phổi trong mô phổi, nhưng ngày nay, nó vẫn là phương pháp định danh sơ bộ nhanh chóng, đơn giản và thiết yếu nhất trong vi sinh lâm sàng. Kỹ thuật này sử dụng hai thuốc nhuộm tương phản crystal violet và safranin để phân loại vi khuẩn thành hai nhóm chính:

Gram dương Gram positive và Gram âm Gram negative dựa trên cấu trúc thành tế bào. Nhuộm Gram giúp chẩn đoán nhanh chóng chỉ trong vài phút, hỗ trợ lựa chọn kháng sinh ban đầu và hướng dẫn các xét nghiệm tiếp theo. Tuy nhiên, phương pháp này có thể bị ảnh hưởng bởi các yếu tố như tuổi của vi khuẩn nên sử dụng mẫu tươi, vi khuẩn đang phát triển tích cực), độ dày của lớp bôi, thời gian tẩy màu, hoặc lỗi kỹ thuật (ví dụ: tẩy màu quá mức có thể làm Gram dương thành Gram âm giả.
Xem thêm về: Trực khuẩn gram dương là gì? Cấu trúc và phân loại như thế nào?
Ý nghĩa lâm sàng của trực khuẩn Gram âm
Trực khuẩn Gram âm là nhóm vi khuẩn đa dạng, chiếm tỷ lệ lớn trong các nhiễm trùng cộng đồng và bệnh viện. Chúng có cấu trúc phức tạp hơn Gram dương, với màng ngoài LPS gây độc tính cao, dẫn đến các phản ứng miễn dịch mạnh mẽ và kháng thuốc phổ biến. Nhuộm Gram đóng vai trò then chốt trong việc phát hiện sớm, giúp phân loại và chọn kháng sinh phù hợp.
Nhuộm Gram từ bệnh phẩm trực tiếp đờm, nước tiểu, khí hư, máu, dịch não tủy giúp phát hiện nhanh hình dạng và Gram âm hồng hoặc đỏ, hỗ trợ chẩn đoán ban đầu.
Phòng ngừa trực khuẩn gram âm
- Vệ sinh tay nghiêm ngặt, đặc biệt ở bệnh viện để tránh lây lan.
- Kiểm soát nhiễm khuẩn: Khử trùng thiết bị y tế, cách ly bệnh nhân MDR.
- Tránh lạm dụng kháng sinh: Chỉ dùng khi cần, theo kháng sinh đồ; chương trình stewardship kháng sinh.
- Tiêm chủng: Vaccine chống Haemophilus, Neisseria meningitidis.
- An toàn thực phẩm: Nấu chín, tránh nước ô nhiễm để ngừa Salmonella, Vibrio.
Trực khuẩn Gram âm không chỉ là nhóm vi khuẩn hình que mà còn đại diện cho sự phức tạp của cấu trúc tế bào prokaryote, với peptidoglycan mỏng và màng ngoài LPS làm chúng bắt màu hồng trong nhuộm Gram. Điều này giải thích tính gây bệnh mạnh mẽ, khó điều trị và nhu cầu chẩn đoán nhanh. Hiểu rõ cơ chế giúp bác sĩ lâm sàng chẩn đoán chính xác, chọn kháng sinh phù hợp và kiểm soát nhiễm trùng hiệu quả hơn, giảm tỷ lệ tử vong.

English
